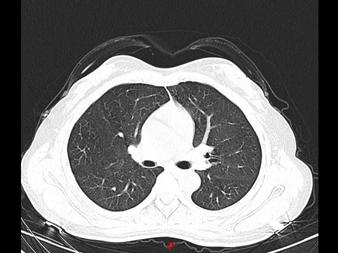
误用84消毒液,84消毒液使用错误事故

大河网讯(记者 何心悦)勤消毒,保持家居环境卫生是再常见不过的事,特别是全民防控新冠肺炎的当下,不少人选择使用84消毒液为家居环境杀菌。84消毒液若使用不规范,甚至会引发过敏性肺泡炎。
点击事实
过度用84消毒液引起致敏性肺泡炎
近日,郑州的张女士和王女士患了同一种“病”,她们感到头晕、乏力,遂到郑州市中心医院就诊。该院医生发现,两人的肺部CT均呈毛玻璃影,与新冠肺炎的表现基本上一模一样,然而二人并没有发烧及咳嗽、咳痰、呼吸困难等症状。
医院当即按照留观处置,等一切安置妥当后,问题又出现了。从CT影像上看虽然非常像新冠肺炎表现,但医生反复追问患者病史了解到,她们并没有新冠肺炎患者接触史,也未去过武汉,小区也没有确诊的患者,她们的症状表现和血象并不符合新冠肺炎……这一度让医生们非常纳闷。
正当大家毫无头绪之时,该院呼吸与危重症医学科主任发现了端倪。原来,两位女士居家期间,因为害怕感染新冠肺炎,每天定时在家喷洒高浓度84消毒液,又没有开窗通风,从而引起过敏性肺泡炎。所幸,经过3天的抗过敏治疗后,二人复查胸部CT,影像基本恢复正常。
过敏性肺泡炎治疗前与治疗后CT影像
过敏性肺泡炎,是指易感人群反复吸入各种具有抗原性的有机粉尘、低分子量化学物质,引起的一组弥漫性间质性肉芽肿性肺病。反复发作可致肺纤维化,甚至可发展为呼吸衰竭。
网友纵论
84消毒液 味道超大,也有想过会不会中毒
有网友回忆起当初自己勤于消毒的场景,有些后怕。@另一个不像自己的天秤:好吓人!有段时间每天回到家我就用84消毒液拖地,威露士洗衣服,酒精喷包包、鞋子、门把手和手机,味道超大……也有想过会不会中毒。
一位网友分享了自己为呼吸顺畅开窗通风的经历。@带壳的大栗子:我妈上周睡前用稀释后的84消毒液给整个屋子拖地,熏得我呼吸困难,就那种闻着闻着好像下一秒会中毒的感觉。实在受不了,起来又用清水拖了一遍,然后打开所有窗户和风扇散味,这才好些。
其实,84消毒液也分好几种,有不刺鼻的。@楚灵子羽:我买的带清香型84消毒液,按说明书用就行,消毒洗衣机都很有效。那种不带香的84消毒液我用不了,太刺鼻。
有的网友,则根本闻不到消毒水的刺鼻气味,因为:@朱肉肉像根草:还好我买回84消毒液基本没怎么喷,因为我懒,是懒癌救了我一命。
这样使用
防止发生不良反应
“84消毒液的主要成分是次氯酸钠,是一种常见的含氯消毒剂。口服、吸入、溅入眼中和皮肤接触均可能引起不良反应。”河南省疾病预防控制中心消毒与媒介生物控制研究所主管医师高丽君告诉记者。
高丽君说:“除了不正确使用可能引发过敏性肺泡炎,吸入后可出现呼吸道刺激症状,如咳嗽、气短、呼吸困难等,严重者可发生化学性支气管炎、化学性肺炎,甚至化学性肺水肿。不小心溅入眼睛会对角膜、结膜产生灼伤作用,出现疼痛、畏光、流泪等。皮肤接触后可出现皮肤局部水疱、红肿、皮疹等接触性皮炎表现。更严重的是,误服84消毒液后会造成口咽、食道和胃的烧灼感,出现恶心、呕吐、烧心、泛酸、腹痛等症状;口服剂量大者可出现循环衰竭、多器官功能衰竭甚至死亡。
84消毒液使用时需严格按照产品说明书要求,现用现配。84消毒液对金属有腐蚀作用,对织物有漂白、脱色作用,对皮肤有刺激作用。金属和有色织物慎用,避免接触皮肤黏膜。
“消费者使用时应注意做好防护,无病患的家庭只要做好日常清洁即可,当怀疑可能受到污染时,可对相应环境物体表面擦拭消毒。配制、分装使用高浓度消毒液时应戴口罩和手套。对桌面、物品表面等使用84消毒液擦拭后,作用30分钟后要用清水擦拭去除消毒液残留。”高丽君说。
在此高丽君特别提醒:84消毒液如不慎溅入眼睛,应立即用水冲洗,严重者应迅速就医;禁止与洁厕灵混用,防止发生危险。高丽君表示,84消毒液严禁口服,应放到孩子不容易摸到的地方;作为强氧化剂,应远离火源、不接触易燃物;置于阴凉、干燥处密封保存,不得与还原物质共储共运。
小知识: 84消毒液为啥叫“84 ” ?
1984年,北京地坛医院的前身北京第一传染病医院的医务人员经3000多次实验,并随着时间的推移、菌类的变化进行了上百次的调整,最终研制出了84消毒液。特别是在1988年,上海甲型肝炎暴发后,84消毒液得到广泛使用,自此被全国人民熟知。